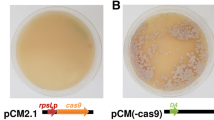

Abstract
Acremonium chrysogenum is an important fungal strain used for cephalosporin C production. Many efforts have been made to develop versatile genome-editing tools to better understand the mechanism of A. chrysogenum. Here, we developed a feasible and efficient CRISPR/Cas9 system. Two genes responsible for the synthesis of yellow pigments (sorbicillinoids) were chosen as targets, and plasmids expressing both the Cas9 protein and single-guide RNAs were constructed. After introducing the plasmids into the protoplasts of A. chrysogenum, 83 to 93% albino mutants harboring the expected genomic alteration, on average, were obtained. We have generated two mutant strains that respectively disrupt sorA and sorB by flexible CRISPR/Cas9 system. We further confirmed that the sorbicillinoid biosynthetic gene cluster is regulated by an autoinduction mechanism. This work will lay a solid foundation for gene function research and regulation in the sorbicillinoid biosynthetic pathway.
Similar content being viewed by others
Avoid common mistakes on your manuscript.
Introduction
Acremonium chrysogenum is important for the industrial production of cephalosporin C, a major intermediate of semisynthetic cephalosporin antibiotics. Despite the availability of the complete genome sequence of A. chrysogenum ATCC 11550 [1], genetic engineering is still challenging in this species. The homologous recombination rate by traditional PEG-mediated protoplast transformation is only around 0.1–1% [2,3,4]. Thus, a feasible and efficient molecular tool is needed to further characterize A. chrysogenum and to extend its practical applications.
The clustered regularly interspaced short palindromic repeats/Cas9 (CRISPR/Cas9) system made gene editing more efficient and precise than before and the mechanism has been explored (Fig. 1). This technology has been applied to various eukaryotes [5], but not to A. chrysogenum. In general, the application of CRISPR/Cas9 to fungi has been a major challenge. The most of well-characterized promoters are transcribed by RNA polymerase II, and they cannot be applied for the production of single-guide RNAs (sgRNAs) due to extensive posttranscriptional processing and modifications after transcription. sgRNAs are produced by RNA polymerase III promoters, such as U3 and U6 snRNA promoters in most in vivo systems. However, these promoters have not been characterized in many species and are not commercially available [6]. In a previous study, an artificial Ribozyme-gRNA-Ribozyme (RGR) structure has been designed, with an sgRNA embedded between a hammerhead (HH)-type ribozyme and a hepatitis delta virus (HDV) ribozyme. In this system, the RGR can be transcribed by RNA polymerase II promoters and undergo self-catalyzed cleavage to liberate the mature gRNA [7].
Overview of type II CRISPR-Cas system. (a, b) Schematic diagram showing the key elements of CRISPR system, which includes trans-activating crRNA, Cas9, and guide crRNA. (c) The transcribed CRISPR array (pre-crRNA) is processed into a single spacer-repeat sequence by a complex that consists of tracrRNA, Cas9, and RNase III. (d) Double strands are cleaved by the complex of Cas9, tracrRNA, and crRNA
Sorbicillinoids are a large family of hexaketide metabolites produced by distantly related fungi, e.g., Trichoderma [8] and Penicillium [9]. They exhibit various beneficial properties, including radical-scavenging activity [10] and anticancer activity [11], among others [12]. A. chrysogenum can produce yellow sorbicillinoids via a polyketide synthase (PKS) cluster [13]. The putative sorbicillinoid gene cluster in A. chrysogenum harbors eight genes (Fig. 2). Among them, two PKS genes, sorA and sorB, have been verified to be essential to build the core structure of sorbicillinoids in other proposed models [14].
Schematic representation of the putative sorbicillinoid gene cluster in A. chrysogenum ATCC 11550, including ACRE_048110 (AM3, auxiliary modifier), ACRE_048120 (sorR2, transcription factor), ACRE_048130 (sorT, transporter), ACRE_048140 (AM2, auxiliary modifier), ACRE_048150 (sorR1, transcription factor), ACRE_048160 (AM3, auxiliary modifier), ACRE_048170 (sorB, non-reducing PKS), and ACRE_048180 (sorA, highly reducing PKS)
In this study, a plasmid expressing all elements needed for the CRISPR/Cas9 system was constructed and introduced into A. chrysogenum to disrupt two PKS genes separately in the putative sorbicillinoid gene cluster in order to investigate their effects on cell metabolism and morphology.
Materials and Methods
Strains and Media
A. chrysogenum CGMCC 3.3795, a wild-type strain, was purchased from the China General Microbiological Culture Collection Center (CGMCC). LPE medium and YPS medium [15] were used for sporulation and protoplast preparation, respectively. Regeneration medium (2 mM MgSO4, 70 mM NaNO3, 7 mM KCl, 11 mM KH2PO4, 10 mg l−1 EDTA, 4.4 mg l−1 ZnSO4·7H2O, 1.01 mg l−1 MnCl2·4H2O, 0.32 mg l−1 CoCl2·6H2O, 0.315 mg l−1 CuSO4·5H2O, 0.22 mg l−1 (NH4)6Mo7O24·4H2O, 1.11 mg l−1 CaCl2, 1 mg l−1 FeSO4·7H2O, 12 g l−1 agar) was used for transformation.
Plasmid Construction
The plasmid template pAN7-sorA was generated as follows:
To express the Cas9 protein in filamentous fungi, the cas9 gene with an N-terminal FLAG tag and a bipartite SV40 NLS signal (NLS-FLAG-Cas9-NLS) was cloned using a pair of primers cas9-F/cas9-R from a commercially available plasmid (PX458) and inserted into the pAN7-1 (purchased from Addgene) vector between the gpdA promoter and trpC terminator, yielding the plasmid pAN7-Cas9.
The artificial gene RGR encoding the pre-gRNA was adopted from a previous study [7] and synthesized by BGI (Shenzhen, China) (Material S1). The synthesized RGR was used as template. The HH ribozyme+sgRNA sequence was amplified using the primers sgsorA-1 and sgsorA-2. The sgRNA+gRNA scaffold+HDV ribozyme sequence was amplified using the primers sgsorA-3 and sgsorA-4. Two fragments were fused by overlapping PCR to generate the RGR structure (Fig. 3). The RGR fragment targeting sorA was inserted between the PgpdA and TtrpC of pAN7-1 with one-step cloning kit (purchased from Vazyme, China), forming the plasmid pAN7-sgRNA (sorA). The sgRNA expression cassette was amplified using primers (sgRNA-F and sgRNA-R) and cloned between the HindIII and NdeI sites of the plasmid pAN7-Cas9, generating the plasmid pAN7-Cas9-sgRNA (sorA).
The hygromycin phosphotransferase gene (hph) for the positive selection of transformants was amplified from pBC-hygro (purchased from Addgene) and inserted into NcoI-digested pAN7-Cas9-sgRNA (sorA), creating the final plasmid, pAN7-sorA.
The RGR fragment targeting sorB was generated by overlap PCR using the primers sgsorB-1, sgsorB-2, sgsorB-3, and sgsorA-4. After double enzyme restriction, the RGR (sorB) was cloned with the same primers (sgRNA-F and sgRNA-R) and inserted between the HindIII and SpeI sites of the pAN7-sorA plasmid, designated pAN7-sorB. Primers are listed in Table S1.
Conditions for Transformation
To introduce the CRISPR/Cas9 vectors into A. chrysogenum, the traditional PEG-mediated method was used, with some modifications.
First, 15 ml of regeneration medium containing hygromycin (150 mg/ml) was added to the transformation plate. Fungal spores were harvested from an LPE culture plate and inoculated into 50 ml of liquid YPS medium for 2 days of cultivation at 28 °C and 220 rpm. The mycelium was harvested by filtering, washed with KMC (600 mM KCl, 25 mM CaCl2·6H2O, 25 mM MgCl2·2H2O), and digested in a lysing enzymes (Sigma, St. Louis, MO, USA) suspension (100 mg in 10 ml of KMC) for 2.5 h with gentle shaking under 120 rpm at 28 °C. Protoplast quality and quantity were checked by microscopy. Protoplasts were separated from cell fragments by filtering through two layers of Miracloth and precipitated at 4000 rpm for 10 min at 25 °C. The protoplasts were washed twice and resuspended in 100 ml of KMC. Then, 10 μg of plasmid DNA and 25 μl of 30% PEG (3 g of PEG 4000 in 10 ml of KMC) were added to the protoplasts. Next, 1 ml of 30% PEG was added to the mixture. After incubation on ice for 5 min, 2 ml of KMC was added to the protoplasts. The suspension was mixed with 50 ml of warm regeneration medium (0.6% agar) containing hygromycin (150 mg/ml) and split into three transformation plates.
Screening, RNA Isolation, and Real-Time Quantitative Polymerase Chain Reaction
Transformants were further validated by sequencing integration regions amplified from Genomic DNA.
The mycelia of strain CGMCC 3.3795, sorA mutant and sorB mutant, were collected after 96 h of cultivation in YPS medium at 28 °C and 220 rpm. Mycelia were ground in liquid nitrogen, and total RNAs of all samples were prepared with Multisource RNA Kit (AxyGen, Union City, CA, USA) following the manufacturer’s instructions. cDNAs were synthesized from approximately 1 μg of total RNA using the PrimeScript™ II 1st Strand cDNA Synthesis Kit (TaKaRa, Shiga, Japan).
Real-time quantitative polymerase chain reaction (RT-qPCR) was performed in 25-μl mixtures in eight-strip PCR tubes using a CFX96 Real-Time PCR Detection System (Bio-Rad, Hercules, CA, USA). PCR was performed using 1× SYBR Premix Ex Taq (TaKaRa). The transcript levels were normalized to the levels of β-actin. Each standard RT-qPCR protocol was performed in triplicate, and the Ct values were determined for optimization. For each gene, the reference sample was set to 1.0, and the results for other samples are expressed as the fold-increase relative to the reference sample. The relative transcript levels were calculated from cycle threshold values using the 2−∆∆CT method [16]. Primers for RT-qPCR are listed in Table S2.
Results
Establishment of a CRISPR/Cas9 System for A. chrysogenum Using an RNA Polymerase II-Based Promoter
Our main aim was to establish a powerful CRISPR/Cas9 system for A. chrysogenum. Wild-type A. chrysogenum produces yellow sorbicillinoids. Based on a BLASTP search against the NCBI database and the genome sequence of the strain ATCC 11550, we found the putative sorbicillinoid gene cluster. The sorA gene encodes a highly reducing (HR) polyketide, and the sorB gene encodes a non-reducing (NR) polyketide, and these form the basic hexaketide scaffold according to previous reports [9]. It is likely that sorA and sorB in A. chrysogenum are required for sorbicillinoid production. As a proof of principle, sorA and sorB were disrupted in subsequent analyses. The sorA and sorB mutants were expected to be white (albino), unlike the wild-type colonies, which exhibit a yellow phenotype.
A. chrysogenum CGMCC 3.3795 and A. chrysogenum ATCC 11550 are both wild-type CPC producing strains. Based on the genome sequence of strain ATCC 11550, primers were designed to amplify the sorA and sorB fragments from A. chrysogenum CGMCC 3.3795. The sequences of fragments completely matched the sequences in strain ATCC 11550 (data not shown). According to this result, PAM sites (-NGG) within an exon and near the AUG start codon were detected and target gRNA sequences were designed separately. The constructed plasmid pAN7-sorA consisted of the following three components (Fig. 4): (1) PgpdA-cas9-TtrpC, in which the cas9 gene obtained from the Streptococcus pyogenes without codon-optimization was used directly, (2) sgRNA expression cassette, consisting of the above-mentioned RGR structure controlled by the PgpdA sequence, and (3) the hph selection marker. The plasmid pAN7-sorB was constructed, as described in the “Materials and Methods.”
Highly Efficient Cas9-Induced sorA and sorB Mutations in A. chrysogenum
To test the efficiency of the newly developed CRISPR/Cas9 system, the plasmids targeting sorA and sorB were transformed into A. chrysogenum by the traditional PEG-mediated method separately. Accordingly, the successful disruption of sorA or sorB could be determined simply by the presence of albino transformants. Only a few colonies were able to grow on the solid selective medium, and in three independent trials, numerous colonies were generated after co-transformation experiments. As the colors of colonies were not obvious on the primary transformation plates (data not shown), they were all subcultured on hygromycin-containing LEP plates to assess their phenotypes in detail.
Since the cleavage induced by Cas9 could be repaired by error-prone non-homologous end-joining (NHEJ) and lead to deletions or small insertions that disrupt the target DNA, we examined two of the albino transformants. Selected transformants were purified by three rounds of sporulation on selective LEP medium. Nucleotide sequencing of the PCR products revealed that we successfully obtained transformants containing sorA mutations and sorB mutations. SorA was disrupted due to a frameshift created by a 1-bp deletion occurring 13 base pairs downstream of the targeted PAM site. One sorB mutant displayed a single nucleotide mutation at the expected site (Fig. 5c).
Inactivation of SorA and SorB, separately, using the CRISPR/Cas9 system. (a) The transformed white colonies on a hygromycin-containing LEP plate. (b) Two different protospacers were individually used to target different genes; a schematic illustration of the diagnostic PCR procedure is provided. (c) Sequence analyses of one sorA mutant and one sorB mutant. The green letters indicate the PAM sequences, the red letters indicate the protospacer sequences, the purple letter indicates mutational nucleotide, and the hyphen indicates deleted nucleotide
The targeting efficiency of CRISPR/Cas9 system can be speculated from the phenotypic ratios. In terms of sorA disruption, most of the colonies could not produce the typical yellow pigment, with a mutation rate of approximately 83% (Fig. 5a). Otherwise for sorB disruption, 13 out of 14 (93%) hygromycin-resistant colonies displayed the expected albino phenotype.
Taken together, these results demonstrated that SpCas9, without optimizing codon usage, could be conditionally expressed in A. chrysogenum and the RGR structure could express the sgRNA with a strong fungal constitutive gpdA promoter. Additionally, the CRISPR/Cas9 system could be applied to wild-type A. chrysogenum with a high efficiency. Simultaneously, these results also confirmed that sorA and sorB are two indispensable PKS genes in sorbicillinoid production.
Decrease in Sorbicillinoid Biosynthesis-Related Gene Expression in Mutants
A. chrysogenum CGMCC 3.3795 produces high levels of sorbicillinoids, causing yellow pigmentation in the culture broth. A study of P. chrysogenum indicated that the sorbicillinoid biosynthetic gene cluster is regulated by an autoinduction mechanism [9]. Accordingly, in the sorbicillinoid biosynthetic mechanism, the loss of sorbicillinoids decreased the expression of genes in the pathway. To test whether the autoinduction mechanism exists in A. chrysogenum, the mycelia of the strain CGMCC 3.3795, sorA mutant and sorB mutant, were collected for RT-qPCR.
As shown in Fig. 6, sorbicillinoid biosynthetic genes were significantly downregulated in both sorA and sorB mutants, other than AM3 and sorR2, for which the expressed levels remained unchanged. These results demonstrated that the deletion of PKS enzymes (SorA and SorB) would lead to a decrease in sorbicillinoid production, consequently causing a marked reduction in the expression levels of genes in the sorbicillinoid biosynthesis gene cluster, consistent with previous observations [9].
Discussion
A. chrysogenum is an important industrial producer of the beta-lactam antibiotic cephalosporin C. However, the genetic engineering is difficult to develop due to the special sexual life cycle and slow growth rate. Many efforts have been made on genome-editing tools, but the existing methods are still time-consuming and inefficient [17]. CRISPR/Cas9 system has been developed in many species with high efficiency, including plants, yeast, and filamentous fungi [18,19,20]. The construct of the system is simple, but it is hard to find the RNA polymerase III-based promoters for gRNA production in fungi. U6 promoter and SNR52 promoter were used in most of the reports [21,22,23]. Some others introduced gRNAs into cells after transcription in vitro due to the lack of suitable promoters [20, 24].
To solve this problem and facilitate genetic manipulation in A. chrysogenum, we applied a simple in vivo CRISPR/Cas9 system with PgpdA to express sgRNA. The core of this system is a plasmid which can express the Cas9 protein, sgRNA, and selection marker simultaneously. The plasmid constructed in this study exhibited big advantages. Only two regions of the plasmid were demanded to be replaced for another target sequence, i.e., the 20-nt protospacer and the first 6 bp of the HH ribozyme inverted repeat of the first six nucleotides of the protospacer, which completes the HH cleavage site (Fig. 3). Two monoenzyme cutting sites (HindIII and SpeI) were reserved between the RGR structure in pAN7-sorA, and the newly designed RGR could easily replace the original one, which is time-saving.
We subsequently disrupted sorA and sorB genes separately. The efficiency of CRISPR/Cas9-mediated gene editing in A. chrysogenum exceeded 80%. The knock-out experiments also confirmed the existence of the sorbicillinoid gene cluster in A. chrysogenum for the first time.
Several models have been proposed about the biosynthesis of sorbicillinoids [14, 25, 26]. Two PKS, two transcription factors, one transport, and three auxiliary modifiers are the core components of this cluster. AM3 (ACRE_048160) encodes a monooxygenase and plays an important role in oxidative dearomatization. AM2 (ACRE_048140) encodes a hydrolase, but no homolog can be identified in other sorbicillinoids-producing strains and the function is unclear. The function of AM1 (ACRE_048110) is also unclear, and it is speculated that AM3 is not essential for the biosynthesis of sorbicillinoids and is involved in other metabolic process [27].
The loss of sorbicillinoids in mutants caused notable decreases in the expression of other sorbicillinoid-related genes, except that the expression level of AM3 was nearly unchanged in the sorA and sorB mutants. It provides evidence for an autoinduction mechanism in A. chrysogenum, but more researches need to be done to explore the roles of these genes and the mechanism of sorbicillinoid biosynthesis.
In summary, we successfully developed a simple CRISPR/Cas9 system for A. chrysogenum, and subsequently sorA and sorB were disrupted with high efficiency. The knock-out experiments also confirmed that these two genes are indispensable in sorbicillinoids production and vertified the autoinduction mechanism in this pathway.
Abbreviations
- CRISPR/Cas9:
-
Clustered regularly interspaced short palindromic repeats/Cas9
- sgRNAs:
-
Single-guide RNAs
- RGR :
-
Ribozyme-gRNA-Ribozyme
- HH:
-
Hammerhead
- HDV:
-
Hepatitis delta virus
- PKS:
-
Polyketide synthase
- CGMCC:
-
China General Microbiological Culture Collection Center
- HR:
-
Highly reducing
- NR:
-
Non-reducing
References
Terfehr, D., Dahlmann, T. A., Specht, T., & Zadra, I. (2014). Genome sequence and annotation of Acremonium chrysogenum, producer of the β-lactam antibiotic cephalosporin C. Genome Announcements, 2, 5.
Poggeler, S., & Kuck, U. (2006). Highly efficient generation of signal transduction knockout mutants using a fungal strain deficient in the mammalian ku70 ortholog. Gene, 378, 1–10.
Hoff, B., Kamerewerd, J., Sigl, C., & Zadra, I. (2010). Homologous recombination in the antibiotic producer Penicillium chrysogenum: strain DeltaPcku70 shows up-regulation of genes from the HOG pathway. Applied Microbiology and Biotechnology, 85(4), 1081–1094.
Bloemendal, S., Loper, D., Terfehr, D., & Kopke, K. (2014). Tools for advanced and targeted genetic manipulation of the beta-lactam antibiotic producer Acremonium chrysogenum. Journal of Biotechnology, 169, 51–62.
Katayama, T., Tanaka, Y., Okabe, T., & Nakamura, H. (2016). Development of a genome editing technique using the CRISPR/Cas9 system in the industrial filamentous fungus Aspergillus oryzae. Biotechnology Letters, 38(4), 637–642.
Zhang, F., Wen, Y., & Guo, X. (2014). CRISPR/Cas9 for genome editing: progress, implications and challenges. Human Molecular Genetics, 23(R1), R40–R46.
Gao, Y., & Zhao, Y. (2014). Self-processing of ribozyme-flanked RNAs into guide RNAs in vitro and in vivo for CRISPR-mediated genome editing. Journal of Integrative Plant Biology, 56(4), 343–349.
Abe, N., Yamamoto, K., & Hirota, A. (2000). Novel fungal metabolites, demethylsorbicillin and oxosorbicillinol, isolated from Trichoderma sp. USF-2690. Bioscience, Biotechnology, and Biochemistry, 64(3), 620–622.
Guzman-Chavez, F., Salo, O., Nygard, Y., & Lankhorst, P. P. (2017). Mechanism and regulation of sorbicillin biosynthesis by Penicillium chrysogenum. Microbial Biotechnology, 10(4), 958–968.
Harned, A. M., & Volp, K. A. (2011). The sorbicillinoid family of natural products: Isolation, biosynthesis, and synthetic studies. Natural Product Reports, 28(11), 1790–1810.
Du, L., Zhu, T., Li, L., & Cai, S. (2009). Cytotoxic sorbicillinoids and bisorbicillinoids from a marine-derived fungus Trichoderma sp. Chemical & Pharmaceutical Bulletin, 57(2), 220–223.
Nicoletti, R., & Trincone, A. (2016). Bioactive compounds produced by strains of Penicillium and Talaromyces of marine origin. Marine Drugs, 14(2), 37.
Druzhinina, I. S., Kubicek, E. M., & Kubicek, C. P. (2016). Several steps of lateral gene transfer followed by events of ‘birth-and-death’ evolution shaped a fungal sorbicillinoid biosynthetic gene cluster. BMC Evolutionary Biology, 16(1), 269.
Derntl, C., Guzman-Chavez, F., Mello-De-Sousa, T. M., & Busse, H. J. (2017). In vivo study of the sorbicillinoid gene cluster in Trichoderma reesei. Frontiers in Microbiology, 8, 2037.
Wang, H., Pan, Y., Hu, P., & Zhu, Y. (2014). The autophagy-related gene Acatg1 is involved in conidiation and cephalosporin production in Acremonium chrysogenum. Fungal Genetics and Biology, 69, 65–74.
Schmittgen, T. D., & Livak, K. J. (2007). Analyzing real-time PCR data by the comparative C(T) method. Nature Protocols, 3, 1101–1108.
Hu, Y., & Zhu, B. (2016). Study on genetic engineering of Acremonium chrysogenum, the cephalosporin C producer. Synthetic and Systems Biology, 1(3), 143–149.
Xie, K., & Yang, Y. (2013). RNA-guided genome editing in plants using a CRISPR-Cas system. Molecular Plant, 6(6), 1975–1983.
DiCarlo, J. E., Norville, J. E., Mali, P., & Rios, X. (2013). Genome engineering in Saccharomyces cerevisiae using CRISPR-Cas systems. Nucleic Acids Research, 41(7), 4336–4343.
Liu, R., Chen, L., Jiang, Y., & Zhou, Z. (2015). Efficient genome editing in filamentous fungus Trichoderma reesei using the CRISPR/Cas9 system. Cell Discovery, 1(1), 15007.
Fuller, K. K., Chen, S., Loros, J. J., & Dunlap, J. C. (2015). Development of the CRISPR/Cas9 system for targeted gene disruption in Aspergillus fumigatus. Eukaryotic Cell, 14(11), 1073–1080.
Arazoe, T., Miyoshi, K., Yamato, T., & Ogawa, T. (2015). Tailor-made CRISPR/Cas system for highly efficient targeted gene replacement in the rice blast fungus. Biotechnology and Bioengineering, 112(12), 2543–2549.
Matsu-Ura, T., Baek, M., Kwon, J., & Hong, C. (2015). Efficient gene editing in Neurospora crassa with CRISPR technology. Fungal Biology and Biotechnology, 2(1), 4.
Pohl, C., Kiel, J. A. K. W., Driessen, A. J. M., & Bovenberg, R. A. L. (2016). CRISPR/Cas9 based genome editing of Penicillium chrysogenum. ACS Synthetic Biology, 5(7), 754–764.
Fahad, A. A., Abood, A., Fisch, K. M., & Osipow, A. (2013). Oxidative dearomatisation: the key step of sorbicillinoid biosynthesis. Chemical Science, 5(2), 523–527.
Abe, N., & Hirota, A. (2002). Chemical studies of the radical scavenging mechanism of bisorbicillinol using the 1,1-diphenyl-2-picrylhydrazyl radical. Chemical Communications, 6, 662–663.
Derntl, C., Rassinger, A., Srebotnik, E., & Mach, L. (2016). Identification of the main regulator responsible for synthesis of the typical yellow pigment produced by Trichoderma reesei. Applied and Environmental Microbiology, 82(20), 6247–6257.
Acknowledgements
We acknowledge our colleague Dr. Liming Ouyang at ECUST China for her constructive discussion on this work.
Funding
This work was financially subsidized by NOW-MoST Joint Program (2013DFG32630) and partially supported by National Basic Research Program (973 program 2012CB721006).
Author information
Authors and Affiliations
Corresponding author
Ethics declarations
We confirm that this manuscript has not been published elsewhere and is not under consideration by another journal. All authors have approved the manuscript and agree with submission to Applied Biochemistry and Biotechnology.
Conflict of Interest
The authors declare that they have no competing interests.
Additional information
Publisher’s Note
Springer Nature remains neutral with regard to jurisdictional claims in published maps and institutional affiliations.
Electronic Supplementary Material
ESM 1
(DOCX 19 kb)
Rights and permissions
About this article
Cite this article
Chen, G., Chu, J. Characterization of Two Polyketide Synthases Involved in Sorbicillinoid Biosynthesis by Acremonium chrysogenum Using the CRISPR/Cas9 System. Appl Biochem Biotechnol 188, 1134–1144 (2019). https://doi.org/10.1007/s12010-019-02960-z
Received:
Accepted:
Published:
Issue Date:
DOI: https://doi.org/10.1007/s12010-019-02960-z